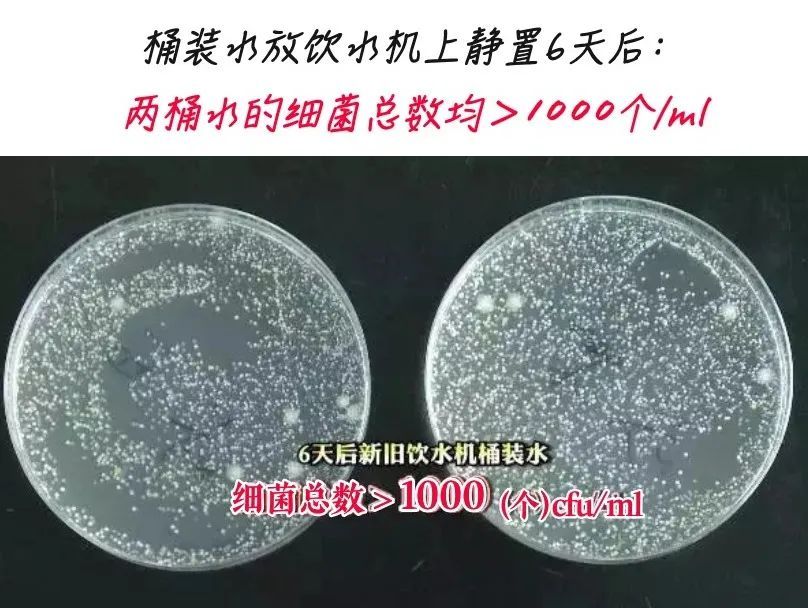

你的位置:1分快3是合法彩票吗 > 新闻动态 > 关于喝水的5个真相,99%的人不知道→
发布日期:2025-05-25 21:25 点击次数:67
提到喝水,不得不提起
那位“水要是不超过90度
自己都不喝”的
董师傅

最终节目组带着董师傅去看医生
一看不知道,看了吓一跳
嘴巴烫的全是水泡

大家千万不要学董师傅哟
其实很多人“不会喝水”
我打赌下面提到的都是你的知识盲区
看完这5个喝水常识
感觉我现在强得可怕
01 每天应该喝1500~1700ml水
根据《中国居民膳食指南(2022)》建议,在温和气候条件下,成年女性轻体力活动水平每天需要喝1500ml,成年男性每天需要喝1700ml。

水喝很少不一定会口渴,但感到口渴时身体已是处于缺水状态,要记得随时补充水分,不要等口渴再喝水,建议喝水一次喝200~300ml。
有高血压合并肾功障碍、高血压合并心衰并发症的患者应当在医生的指导下饮水。
健康提示:水也不是喝的越多越好,过多的摄入容易造成肾脏的额外压力或发生水中毒。

02 喝水的最佳水温在10~40℃
《中国居民膳食指南(2022)》建议饮水的适宜温度在10~40℃,接近于凉白开。
刚出锅的汤、刚泡好的咖啡/茶饮,温度为80~95℃,不宜直接饮用哦。世界卫生组织、国际癌症机构都曾经提示,饮用65℃以上热饮,会烫伤食管黏膜、增加患食管癌的风险。

而饮用温度过低的水,尤其大量饮用冰水会造成肠胃血管突然收缩,使供给肠胃的血液突然减少,并可能会导致胃痉挛、腹痛、腹泻等情况。

03 含糖饮料不可以代替饮用水
含糖饮料的主要成分是水和添加糖,营养价值、营养素密度低。过多摄入含糖饮料可增加龋齿、超重肥胖、2型糖尿病、血脂异常的发病风险。因此,建议用白水或淡茶水替代含糖饮料。
有些人(尤其是儿童)不喜欢喝没有味道的水,可以在水中加入1~2片新鲜柠檬片、3~4片薄荷叶等增加水的色彩和味道。也可以自制一些传统饮品,如绿豆汤、酸梅汤等,注意不要添加糖。
04 不建议长期只喝纯净水
纯净水指的是不含有杂质或细菌的水,是以符合生活饮用水卫生标准的水为原水。
通过离子交换、反渗透等加工方法制成,去除了水中有害物质的同时,也去除了对人体有益的矿物质和微量元素。

饮用水中的矿物质对人体健康至关重要,不论饮食结构如何丰富,人体都需要从饮用水中摄取一部分矿物元素。虽然纯净水相对安全,但如果只喝纯净水,尤其对于膳食中缺乏矿物质的人,会存在各种潜在的健康风险。
有研究显示,纯净水中钙、镁含量较低,长期饮用可能会增加心血管疾病风险,亦可能对骨质健康有不利影响。

05 桶(瓶)装水可能不卫生
与自来水相比,桶(瓶)装水被认为干净、安全。然而,我国某地质量监督部门抽检204批次桶(瓶)装饮用水产品,不合格率为14.22%。
桶(瓶)装水的质量不单与生产环节有关,水源、水桶(瓶)、使用过程中等任何一个环节都有可能造成污染。

▲图源:央视新闻
因此,在选购和使用桶(瓶)装饮用水时应注意以下几点:
①应购买标注有质量安全认证、市场上有一定知名度的桶(瓶)装饮用水,千万不要购买无证产品。

②即使是质量较好的桶(瓶)装饮用水,开封后放置时间太长也易滋生细菌,因此应尽量在最短时间内喝完;人数少的家庭可选用容量较小的桶(瓶)装水,缩短饮用时间,以保证安全卫生。
③桶装水如配合饮水机使用时,要注意仔细清洗饮水机内胆。
Powered by 1分快3是合法彩票吗 @2013-2022 RSS地图 HTML地图